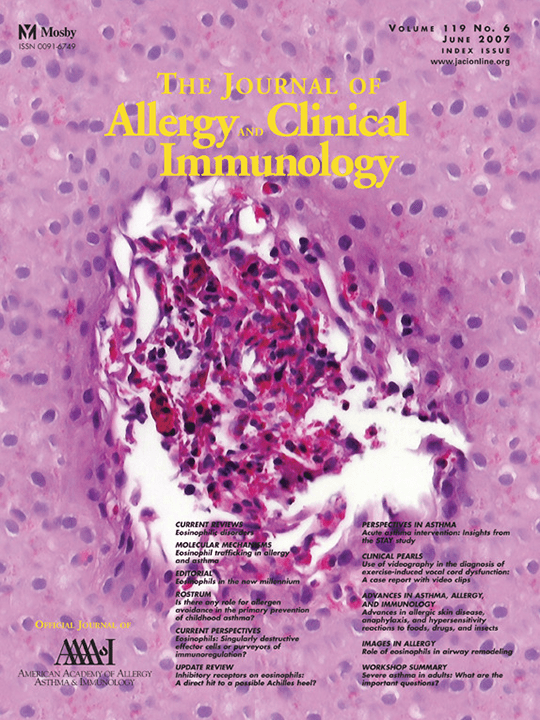
Journal of Allergy and Clinical Immunology June 2007 cover image.

Allergy and Immunology Research Highlights
Our research within the Division of Allergy and Immunology spans:
- fundamental studies
- translational investigations
- genetic and genomic analyses
- big data analyses (informatics)
- clinical trials
Novel models of immunologic diseases, developed and / or fine-tuned by divisional researchers, provide unprecedented systems to investigate key inflammatory steps involved in allergic and immunological disease and to enhance our understanding of adaptive and innate immunity, including analyses of individuals, with a focus on mast cells, eosinophils, macrophages and lymphocytes.